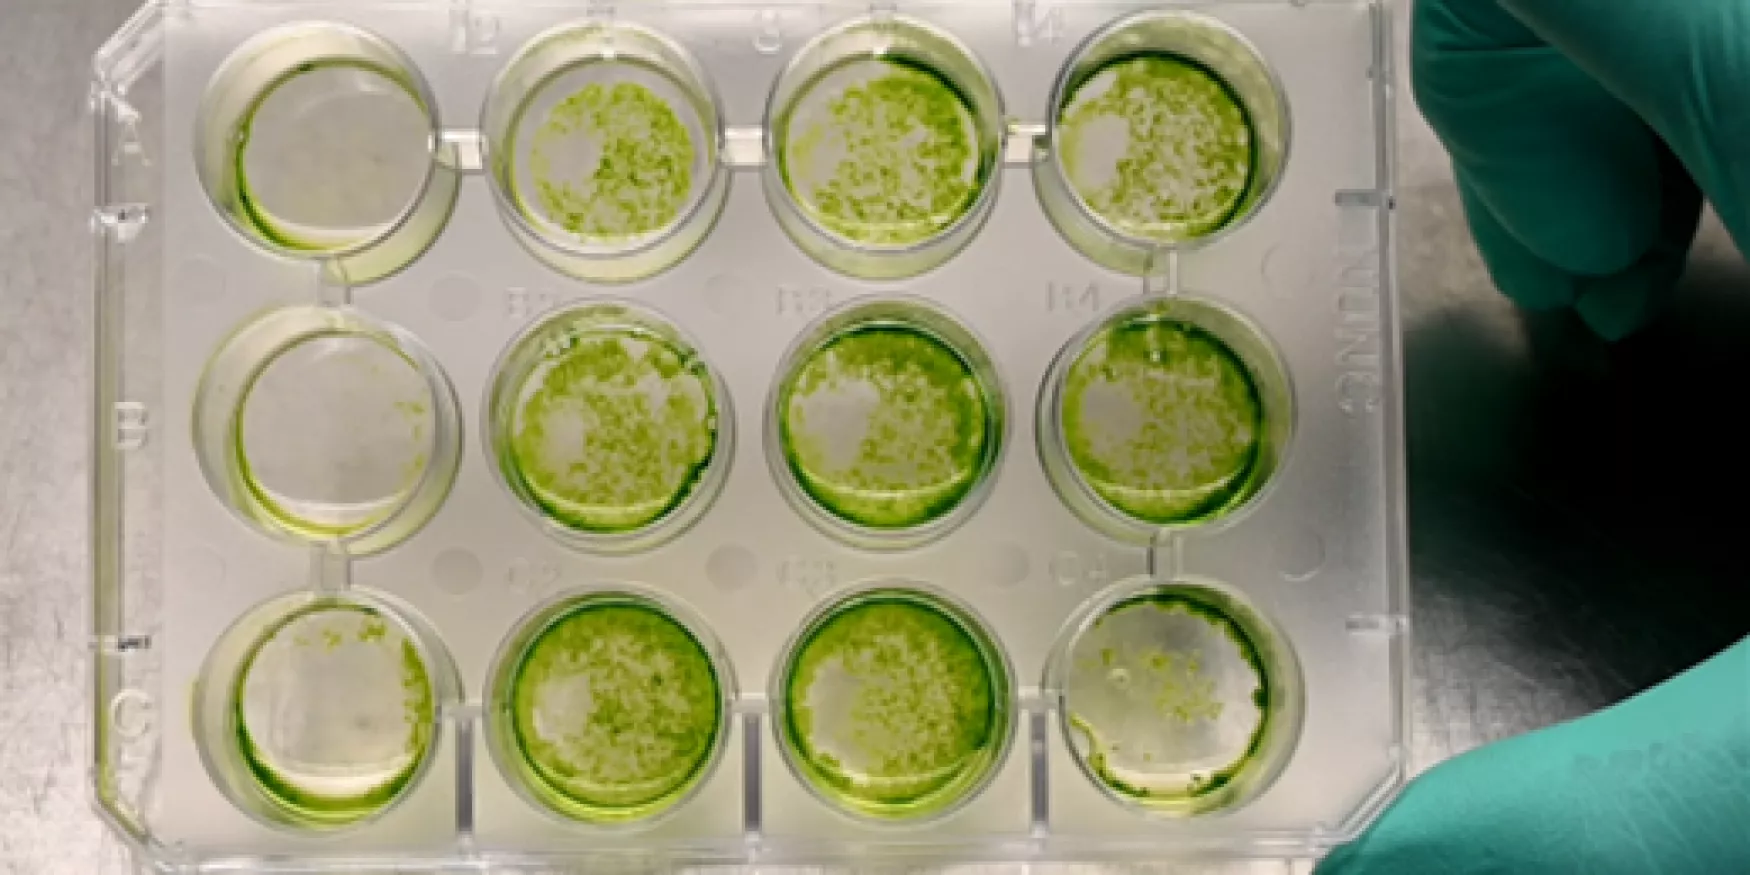

Living materials
Living materials (or Hybrids cell-materials) are defined as engineering materials composed of living cells interacting with their environment and capable of multiplying and carrying out their own metabolism.
Genetically modified living materials use living cells as "material scaffolding" and constitute a new class of materials that could be used in bioelectronics, bio-sensing, bio-production, bio-catalysis, waste water treatment, cell therapy, etc.
Our strengths :
- Materia Nova has solid experience in the design of living engineered materials, which refers to a range of multidisciplinary expertise, including bioprocess regulation, biological screening, cell encapsulation, design and synthesis of biocompatible materials, etc.
- Materia Nova can provide a multidisciplinary platform for the characterization and performance evaluation of living modified materials in order to study the properties selected and optimize their effectiveness in applications.